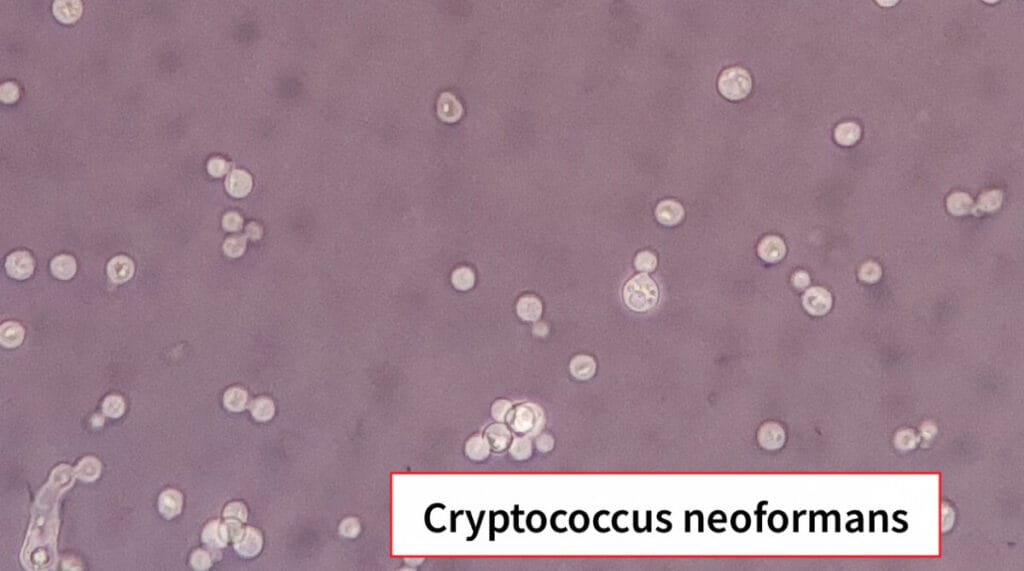

Table of Contents
진균의 분류 (Classification of Fungi)
진균(Fungi)은 진핵생물로, 세포벽은 키틴(Chitin)으로 구성되어 있으며, 세포막에는 에르고스테롤(Ergosterol)이 존재합니다. 진균은 영양섭취 방식, 형태, 생식 방법에 따라 다양하게 분류되는데, 의학적으로 중요한 진균은 크게 효모(Yeasts), 사상균(Molds), 그리고 이형성 진균(Dimorphic fungi)으로 나눌 수 있습니다.
효모 (Yeasts)
단세포로 존재하는 진균으로, 주로 원형 또는 난형이며 발아(budding)나 분열(fission)로 증식합니다.
- 단세포 원형 또는 타원형 구조로, 현미경에서 균사가 관찰되지 않음
- 출아(budding) 또는 이분법으로 무성생식
| Candida albicans |
| 🟩 구강, 질, 소화관 등에 정상 상재하지만 면역저하 시 칸디다증을 일으킵니다. |
| Cryptococcus neoformans |
| 🟩 두꺼운 피막을 가진 효모로, 흡입 시 폐 감염 후 뇌수막염을 유발할 수 있습니다. |

사상균 (Molds)
다세포성 필라멘트 구조(균사, hyphae)를 이루며, 포자를 형성하여 번식합니다.

- 다세포 형태의 진균으로, 세포가 사상(hyphae) 구조를 이루어 집합한 균사체(mycelium)를 형성
- 분절 여부에 따라 격막성(septate)과 비격막성(non-septate)으로 구분됨
- 분생포자(conidia)나 포자(spore)를 형성하여 번식
| Aspergillus fumigatus |
| 🟧 공기 중 포자를 흡입 시 폐 아스페르길루스를 유발할 수 있습니다. |
| Rhizopus spp. |
| 🟧 기회감염균으로, 당뇨 환자에서 턱뼈·안와 점막곰팡이증을 일으킬 수 있습니다. |
| Mucor spp. |
| 🟧 환경에 흔히 존재하며, 면역저하 환자에서 점막곰팡이증을 유발할 수 있습니다. |




이형성 진균 (Dimorphic Fungi)
온도에 따라 형태가 바뀌는 진균으로, 환경에서는 사상균 형태, 인체 내에서는 효모 형태로 존재합니다.
- 환경 조건(주로 온도)에 따라 효모 형태와 사상균 형태를 모두 취할 수 있는 진균
- 25℃에서는 사상균 (Mold) 형태, 37℃에서는 효모 (Yeast) 형태로 변환
- 주로 인체 감염 시 효모 형태로 존재하며, 병원성을 나타냄
| Blastomyces dermatitidis |
| 🟦 북미 지역에 주로 분포하며, 흡입 시 폐 감염 후 피부, 뼈로 전이될 수 있습니다. |
| Coccidioides immitis/posadasii |
| 🟦 건조한 토양에서 발견되며, 흡입 시 발열, 기침, 발진이 동반되는 Coccidiodomycosis를 유발합니다. |
| Histoplasma capsulatum |
| 🟦 조류·박쥐 배설물이 많은 곳에서 서식하며, 폐 감염과 전신 감염을 일으킬 수 있습니다. |
| Paracoccidioides brasiliensis/lutzii |
| 🟦 남미 지역에 주로 분포하며, 폐 감염 후 점막·피부 병변이 나타날 수 있습니다. |
| Sporothrix schenckii |
| 🟦 가시나 토양을 통해 피부에 침투하며, 림프관을 따라 피부 병변이 퍼집니다(스포로트리코시스). |
| Talaromyces marneffei |
| 🟦 동남아시아에 주로 분포하며, HIV 감염자 등 면역저하 환자에서 심한 전신 감염을 유발합니다. |

. 2015 Aug;5(8):a019794. doi: 10.1101/cshperspect.a019794. PMID: 25384771; PMCID: PMC4526722.

